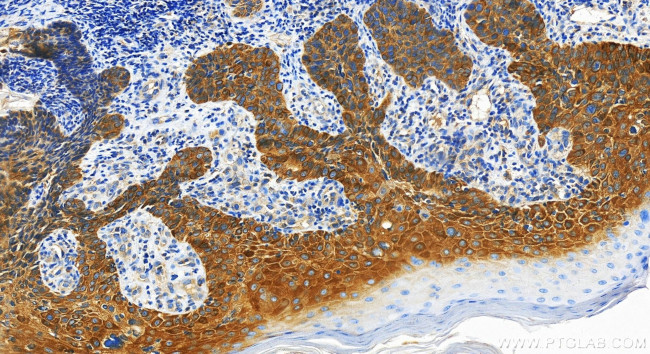
GSDMC Antibody in Immunohistochemistry (Paraffin) (IHC (P))

Search
Proteintech
GSDMC Polyclonal Antibody
{{$productOrderCtrl.translations['antibody.pdp.commerceCard.promotion.promotions']}}
{{$productOrderCtrl.translations['antibody.pdp.commerceCard.promotion.viewpromo']}}
{{$productOrderCtrl.translations['antibody.pdp.commerceCard.promotion.promocode']}}: {{promo.promoCode}} {{promo.promoTitle}} {{promo.promoDescription}}. {{$productOrderCtrl.translations['antibody.pdp.commerceCard.promotion.learnmore']}}
产品信息
30469-1-AP
种属反应
宿主/亚型
分类
类型
抗原
偶联物
形式
浓度
规格
纯化类型
保存液
内含物
保存条件
运输条件
产品详细信息
Immunogen sequence: VHILPVGRIE EPFWQNFKHL QEEVFQKIKT LAQLSKDVQD VMFYSILAML RDRGALQDLM NMLELDSSGH LDGPGGAILK KLQQDSNHAW FNPKDPILYL LEAIMVLSDF QHDLLACSME KRILLQQQEL VRSILEPNFR YPWSIPFTLK PELLAPLQSE GLAITYGLLE ECGLRMELDN PRSTWDVEAK MPLSALYGTL SLLQQLAEA
靶标信息
The N-terminal moiety promotes pyroptosis. May be acting by homooligomerizing within the membrane and forming pores (PubMed:27281216). The physiological relevance of this observation is unknown (Probable). [UniProt]
仅用于科研。不用于诊断过程。未经明确授权不得转售。
篇参考文献 (0)
生物信息学
蛋白别名: Gasdermin-C; melanoma-derived leucine zipper, extra-nuclear factor; Melanoma-derived leucine zipper-containing extranuclear factor
基因别名: GSDMC; MLZE
UniProt ID: (Human) Q9BYG8
Entrez Gene ID: (Human) 56169